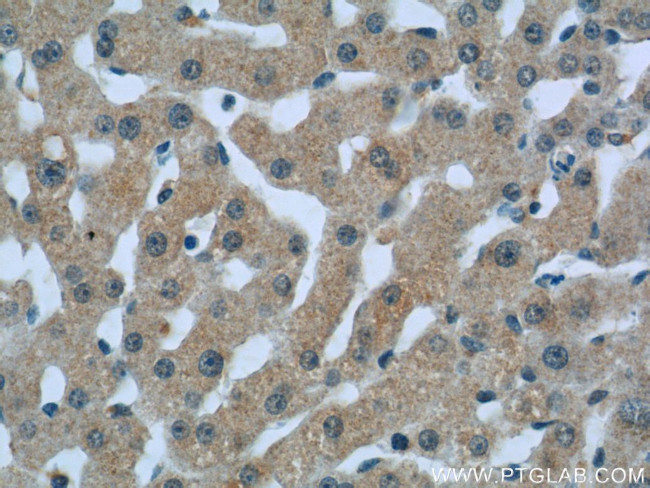
C1qC Antibody in Immunohistochemistry (Paraffin) (IHC (P))

Search
Proteintech
C1qC Polyclonal Antibody
{{$productOrderCtrl.translations['antibody.pdp.commerceCard.promotion.promotions']}}
{{$productOrderCtrl.translations['antibody.pdp.commerceCard.promotion.viewpromo']}}
{{$productOrderCtrl.translations['antibody.pdp.commerceCard.promotion.promocode']}}: {{promo.promoCode}} {{promo.promoTitle}} {{promo.promoDescription}}. {{$productOrderCtrl.translations['antibody.pdp.commerceCard.promotion.learnmore']}}
产品信息
16889-1-AP
种属反应
宿主/亚型
分类
类型
抗原
偶联物
形式
浓度
规格
纯化类型
保存液
内含物
保存条件
运输条件
产品详细信息
This antibody is raised against C1qC which is the C-chain polypeptide of human complement subcomponent C1q.
Immunogen sequence: QANTGCYGI PGMPGLPGAP GKDGYDGLPG PKGEPGIPAI PGIRGPKGQK GEPGLPGHPG KNGPMGPPGM PGVPGPMGIP GEPGEEGRYK QKFQSVFTVT RQTHQPPAPN SLIRFNAVLT NPQGDYDTST GKFTCKVPGL YYFVYHASHT ANLCVLLYRS GVKVVTFCGH TSKTNQVNSG GVLLRLQVGE EVWLAVNDYY DMVGIQGSDS VFSGFLLFPD (27-245 aa encoded by BC009016)
靶标信息
This gene encodes a major constituent of the human complement subcomponent C1q. C1q associates with C1r and C1s in order to yield the first component of the serum complement system. A deficiency in C1q has been associated with lupus erythematosus and glomerulonephritis. C1q is composed of 18 polypeptide chains: six A-chains, six B-chains, and six C-chains. Each chain contains a collagen-like region located near the N-terminus, and a C-terminal globular region. The A-, B-, and C-chains are arranged in the order A-C-B on chromosome 1. This gene encodes the C-chain polypeptide of human complement subcomponent C1q. Alternatively spliced transcript variants that encode the same protein have been found for this gene.
仅用于科研。不用于诊断过程。未经明确授权不得转售。
生物信息学
蛋白别名: Complement C1q subcomponent subunit C; complement component 1, q subcomponent, C chain; complement component 1, q subcomponent, gamma polypeptide; unnamed protein product
基因别名: C1Q-C; C1QC; C1QD3; C1QG
UniProt ID: (Human) P02747
Entrez Gene ID: (Human) 714